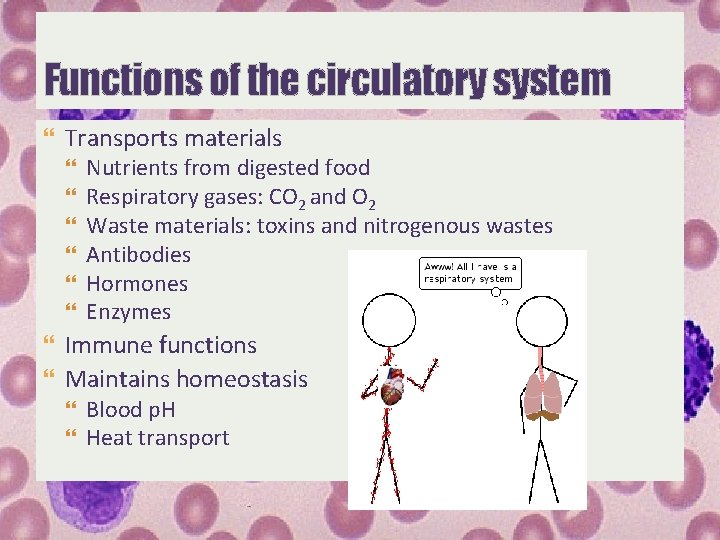
Functions of the circulatory system Transports materials Nutrients from digested food Respiratory gases: CO

Transport systems in animals Well be discussing Functions

Transport systems in animals

We’ll be discussing Functions of a transport/circulatory system Invertebrate circulation 1. 2. a. Diffusion b. Aided by gastrovascular cavity c. Water vascular system Open circulatory system Closed circulatory system d. e. Vertebrate circulation 3. a. b. Fishes Amphibians c. Reptiles d. Birds e. Mammals 1) 2) 3) 4) 5) 6) 7) Pathway of blood Cardiac cycle Maintenance of heartbeat Principles governing blood circulation Lymphatic system Blood composition and function Cardiovascular disease
Functions of the circulatory system Transports materials Nutrients from digested food Respiratory gases: CO 2 and O 2 Waste materials: toxins and nitrogenous wastes Antibodies Hormones Enzymes Immune functions Maintains homeostasis Blood p. H Heat transport

How are materials transported in multicellular organisms? Phylum Porifera

How are materials transported in multicellular organisms? Gastrovascular cavity in simple invertebrates Cnidarians (e. g. Hydra) and flatworms (e. g. planarians) No system required Single opening: exchange of materials with the environment Central cavity for digestion and distribution of substances throughout the body Body walls two cell layers thick materials undergo diffusion

How are materials transported in multicellular organisms? Water vascular system in echinoderms multi-purpose: locomotion, food and waste transport, respiration movement of muscles pump water into canals closed system of canals connecting tube feet madreporite ring canal radial and lateral canal tube feet ampullae

How are materials transported in multicellular organisms? Open circulatory system Phylum Arthropoda, Phylum Mollusca (with one exception) hemolymph heart(s) sinuses ostia heart(s) diffusion from sinuses to organs often serve a support purpose disadvantage: loss of pressure in sinuses insects: well-developed respiratory systems, O 2 not transported through the blood

How are materials transported in multicellular organisms? Closed circulatory system or cardiovascular system cephalopods, annelids, vertebrates presence of blood vessels advantages 1. rapid flow 2. may direct blood to specific tissues 3. blood cells and large molecules remain within vessels 4. can support higher levels of metabolic activity

General plan of the cardiovascular system Heart Atrium Ventricle Blood vessels Arteries Arterioles Capillaries and capillary beds Venules Veins Blood

Vertebrate adaptations of the cardiovascular system FISHES Single-circulation Fish heart 2 -chambered atrium and ventricle African lungfish heart 3 -chambered 2 atria LA: O 2 -rich blood RA: O 2 -poor blood spiral fold partially divided ventricle

Vertebrate adaptations of the cardiovascular system Amphibians Pulmocutaneous and systemic circulation are partly separated Amphibian heart 1 ventricle 2 atria: LA: O 2 -rich blood RA: O 2 -poor blood advantage: oxygen-rich blood reaches the body’s organs faster disadvantage: some mixing of O 2 -rich and poor blood occurs

Vertebrate adaptations of the cardiovascular system Reptiles Reptilian heart 3 -chambers (crocodilians have 4) 2 atria 1 ventricle (2 in crocodiles and alligators) partially divided, decreases mixing

Birds and Mammals 4 chambered heart: 2 atria 2 ventricles full separation of pulmonary and systemic circuits Advantages 1. 2. 3. no mixing of oxygenated and deoxygenated blood gas exchange is maximized pulmonary and systemic circuits operate at different pressures Importance 1. Endothermic high nutrient and O 2 demands in tissues 2. Numerous vessels great deal of resistance, so requires high pressure Vertebrate adaptations of the cardiovascular system

Blood flow in mammals R side of heart: pulmonary circuit L side of heart: systemic circuit one way valves: atrioventricular valves semilunar valves

1. right atrium receives O 2 poor blood from superior and inferior venae cavae 2. from right atrium into the right ventricle through the tricuspid valve 3. pumped into the pulmonary artery through the pulmonary semilunar valve to lungs 4. O 2 -rich blood from lungs is returned to the left atrium via the pulmonary veins 5. enters the left ventricle via the mitral or bicuspid valve 6. exits the left ventricle into the aorta via the aortic semilunar valve 7. circulated to body tissues Blood flow in mammals
- Slides: 15